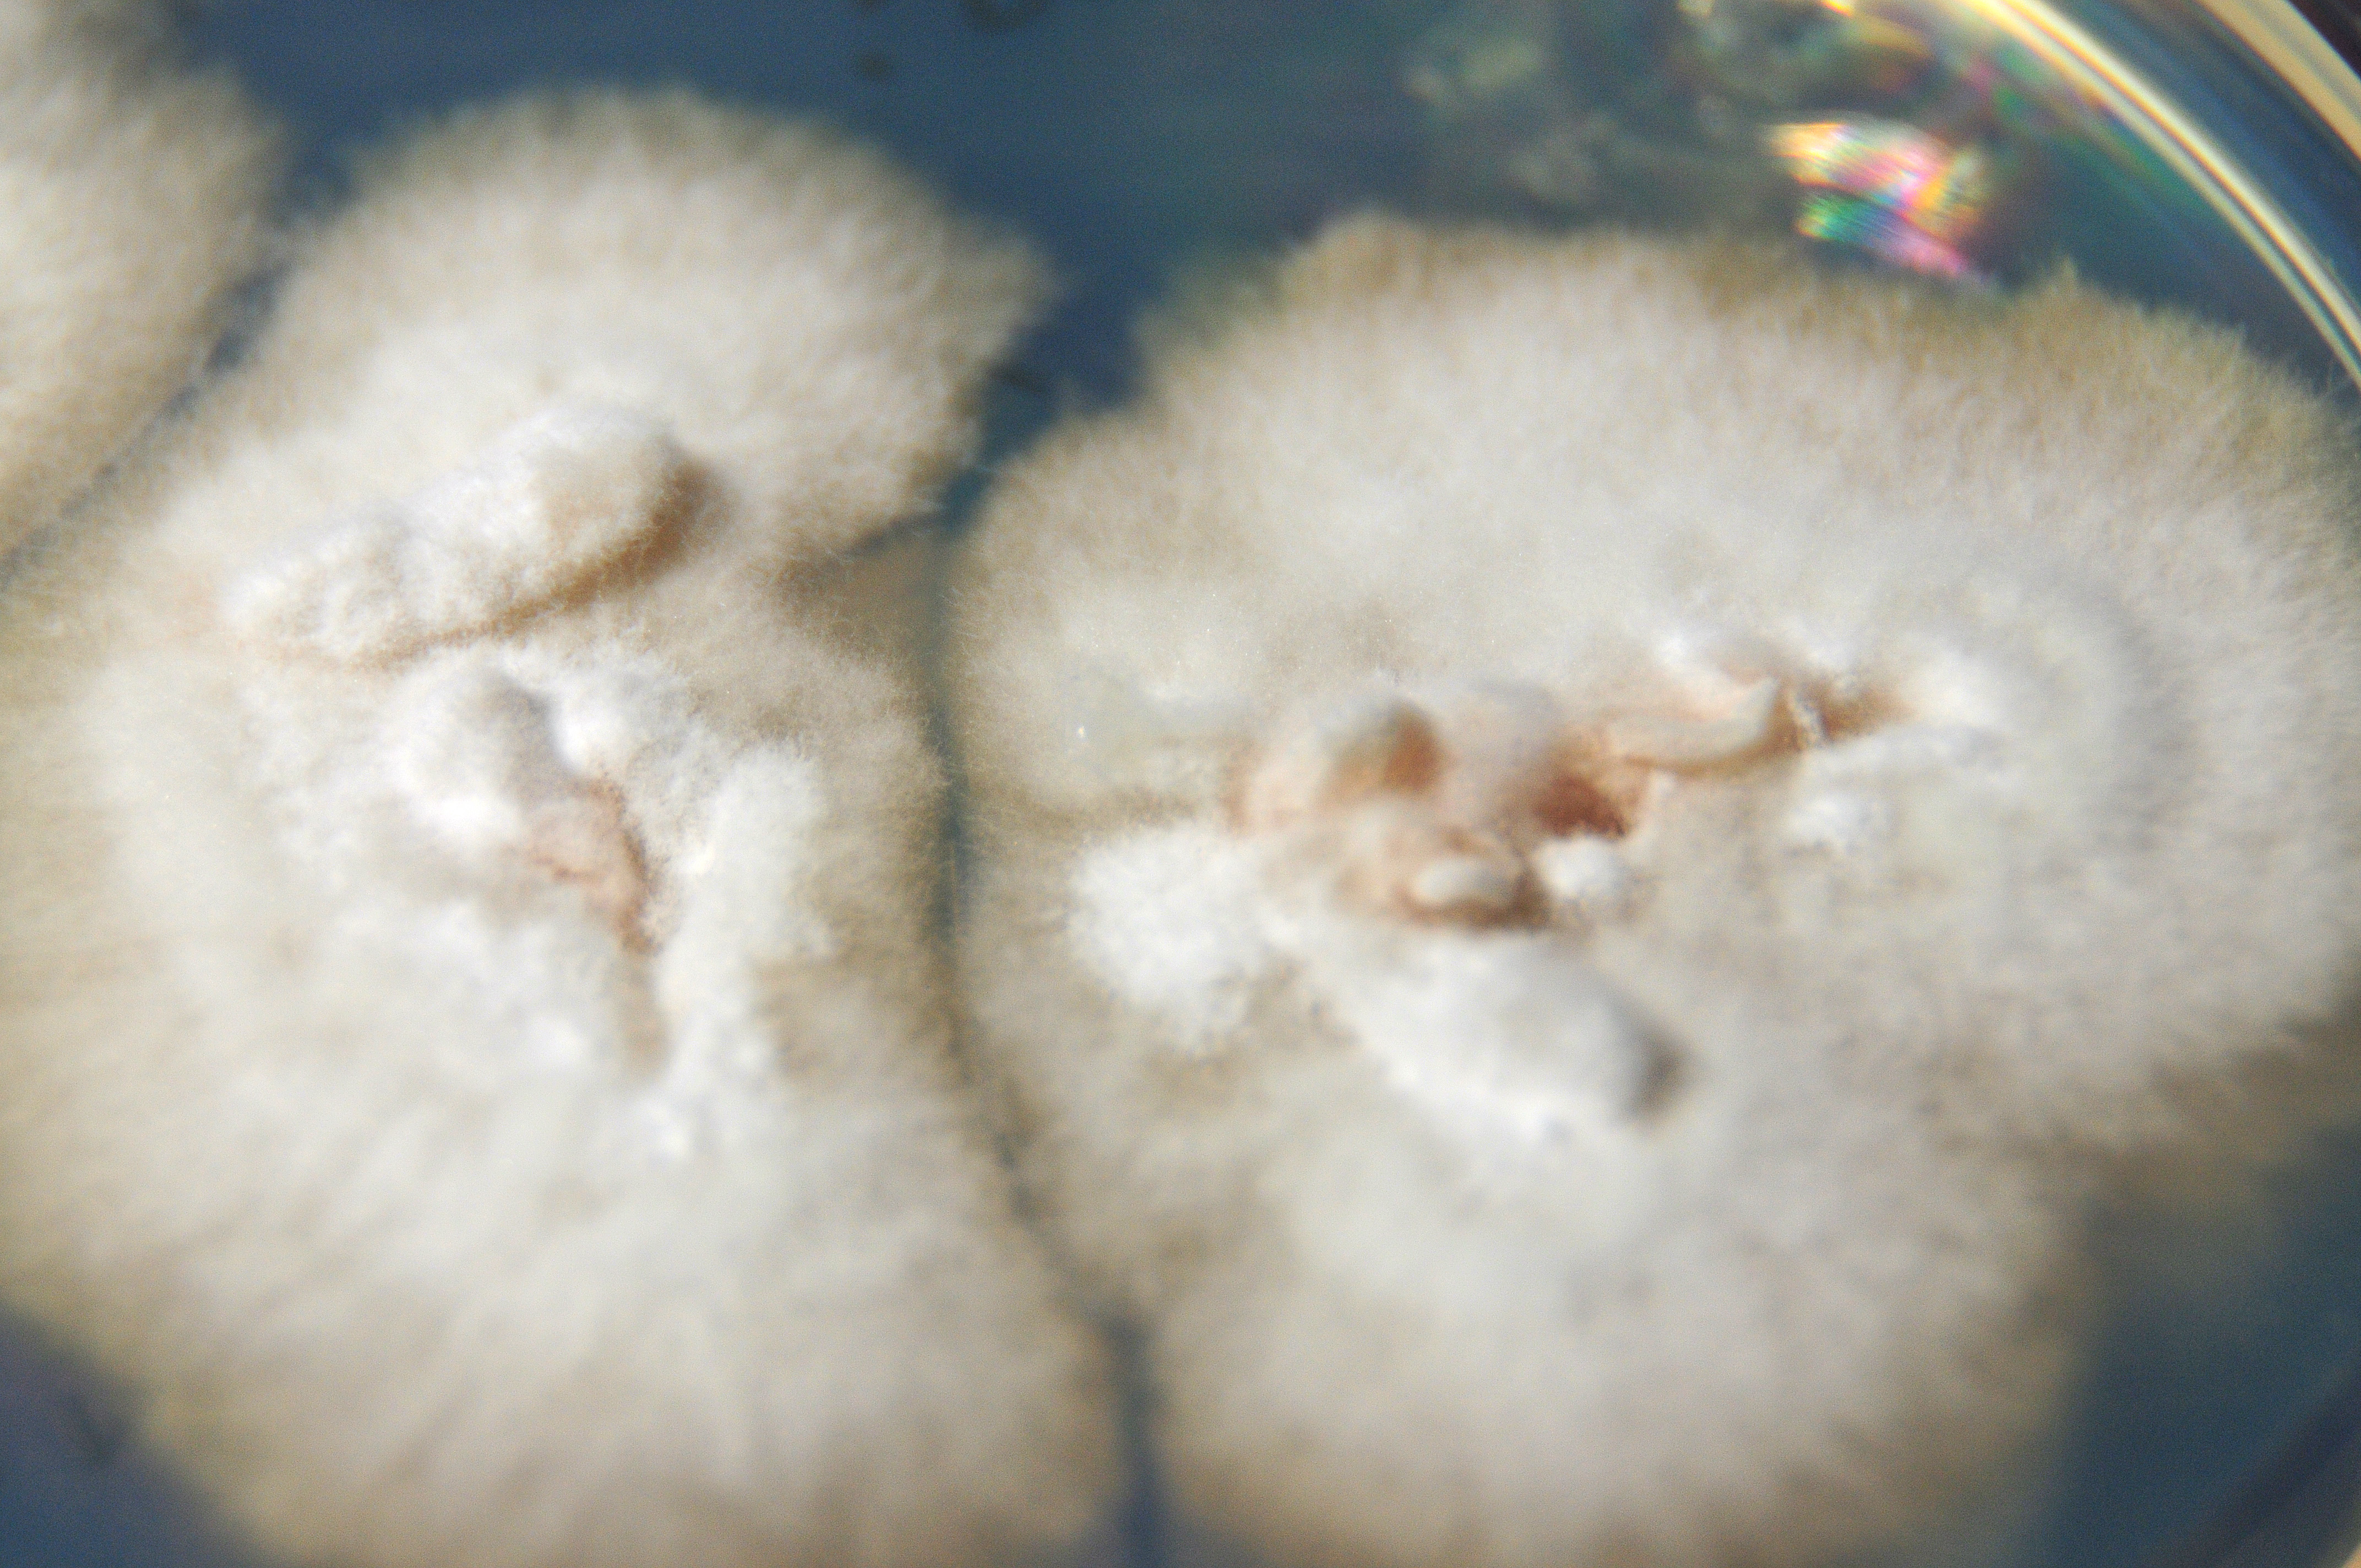
None
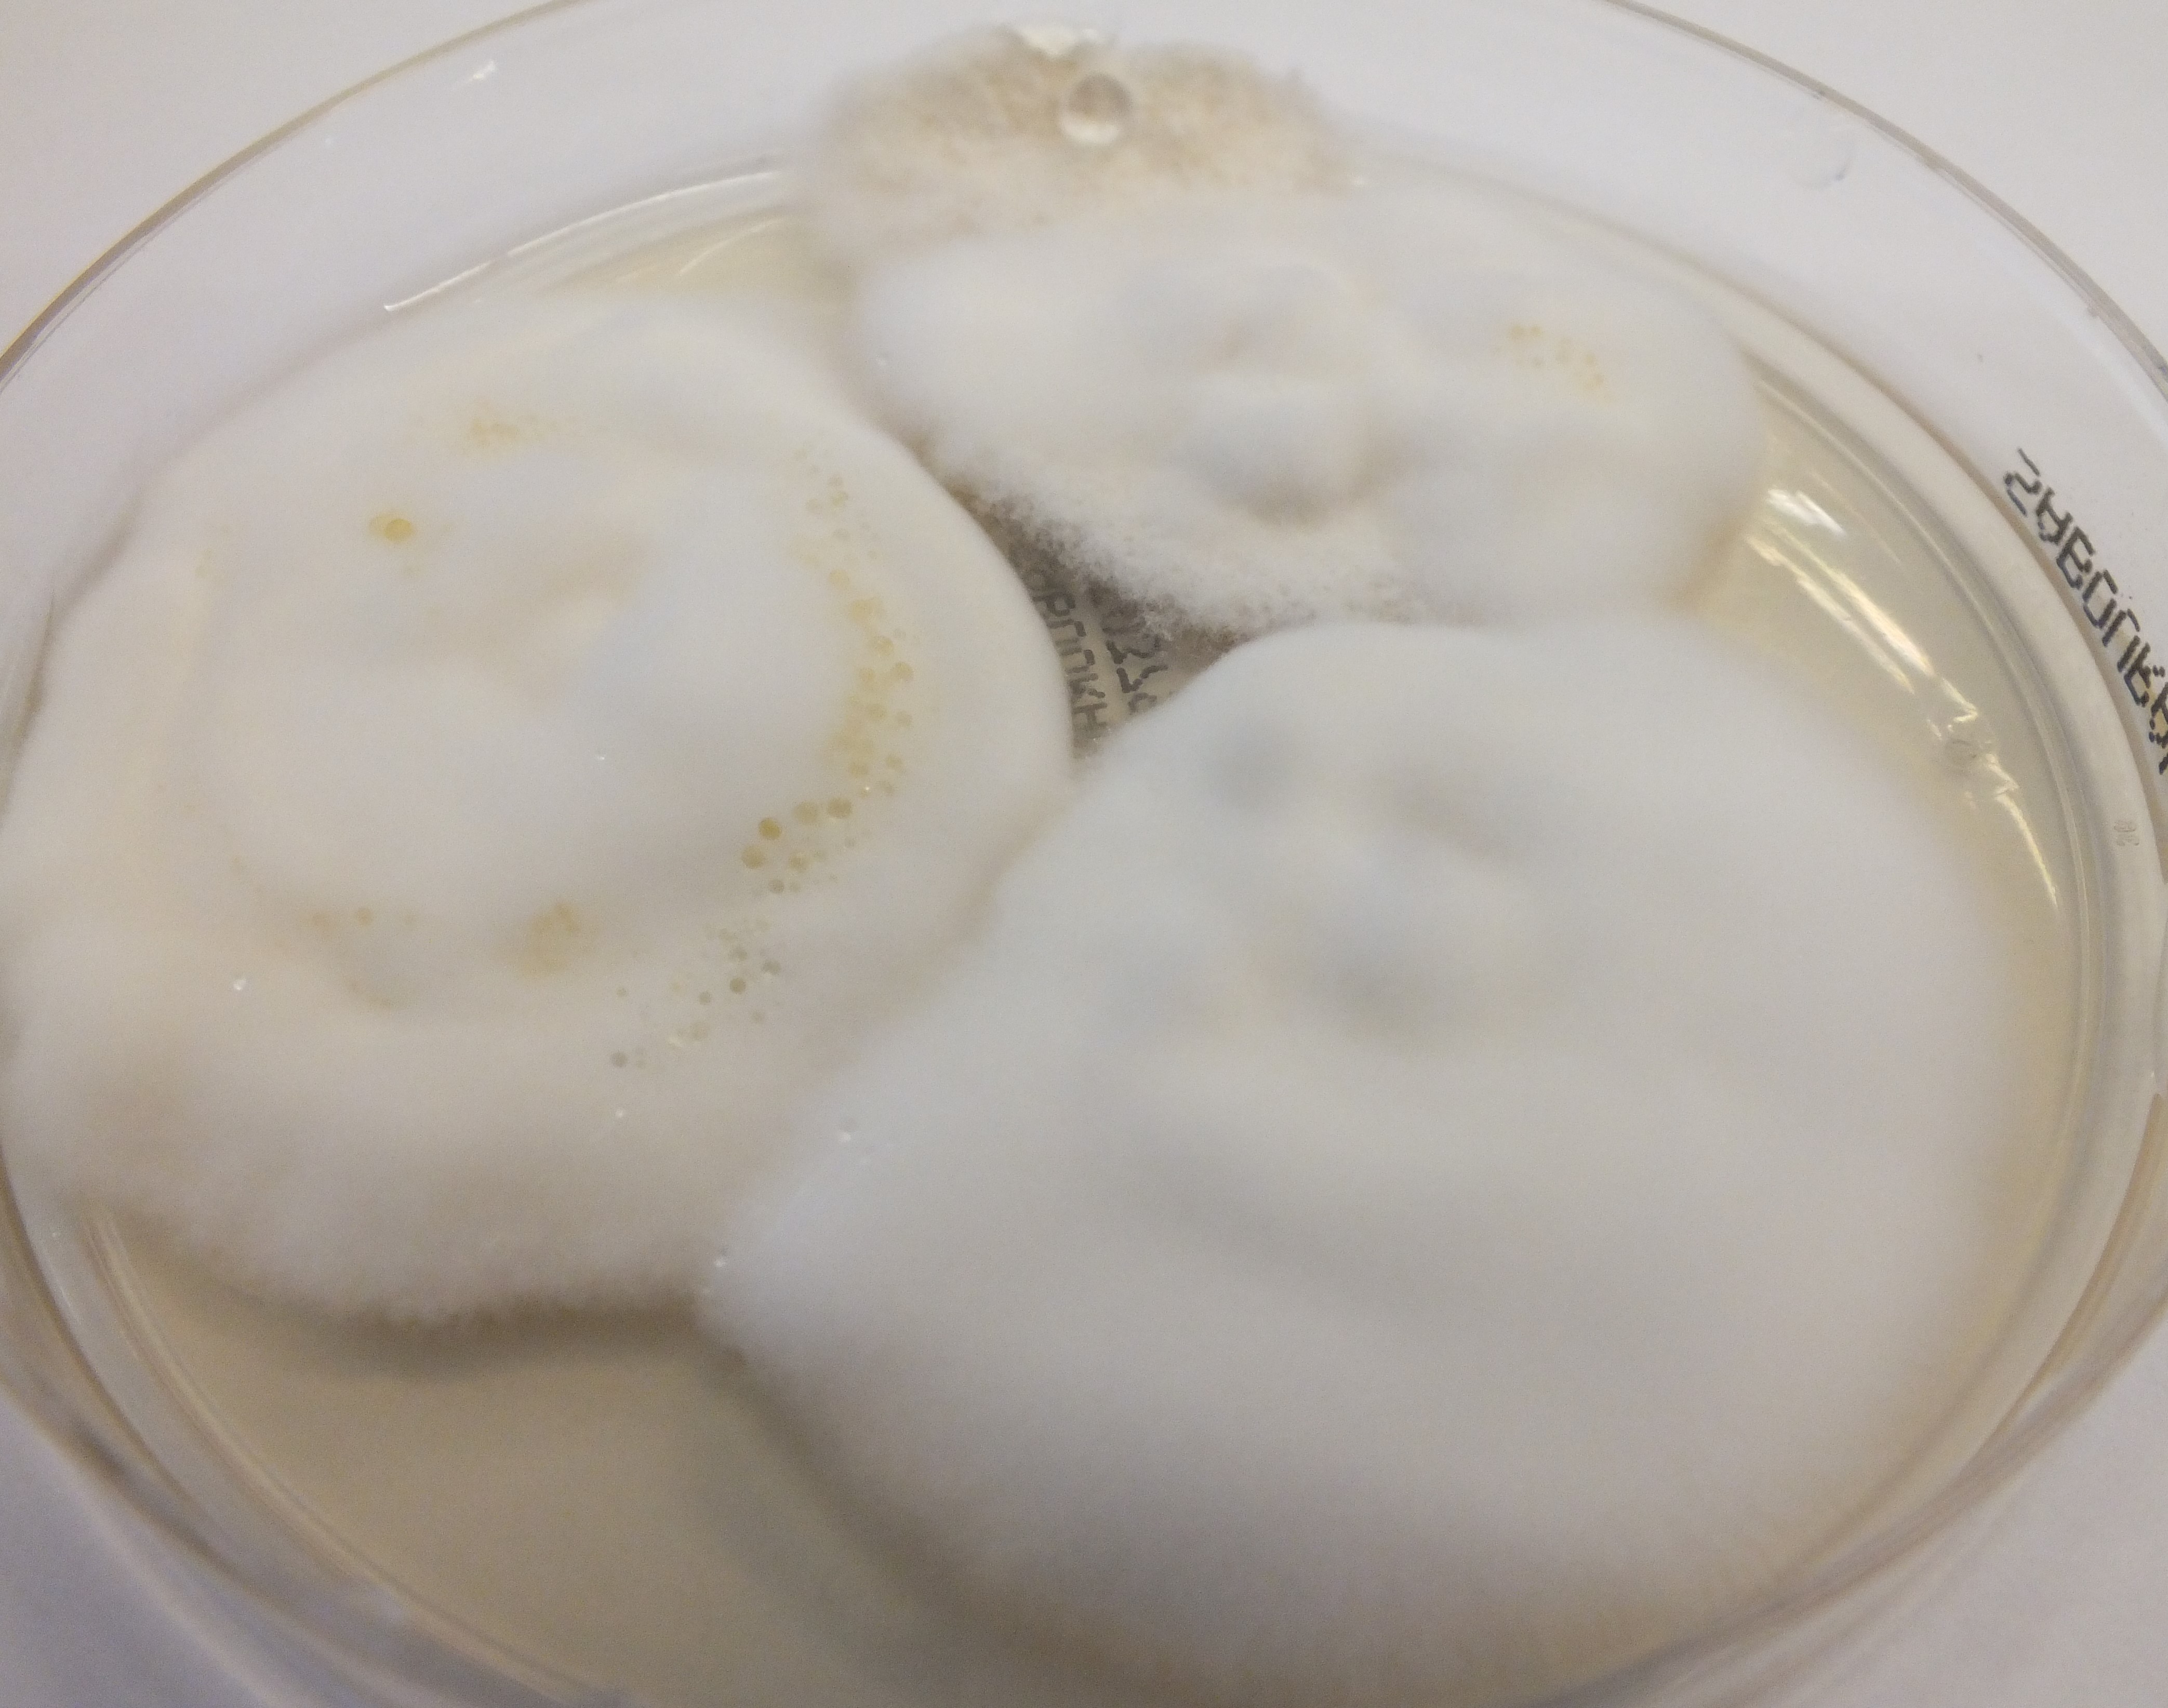
None
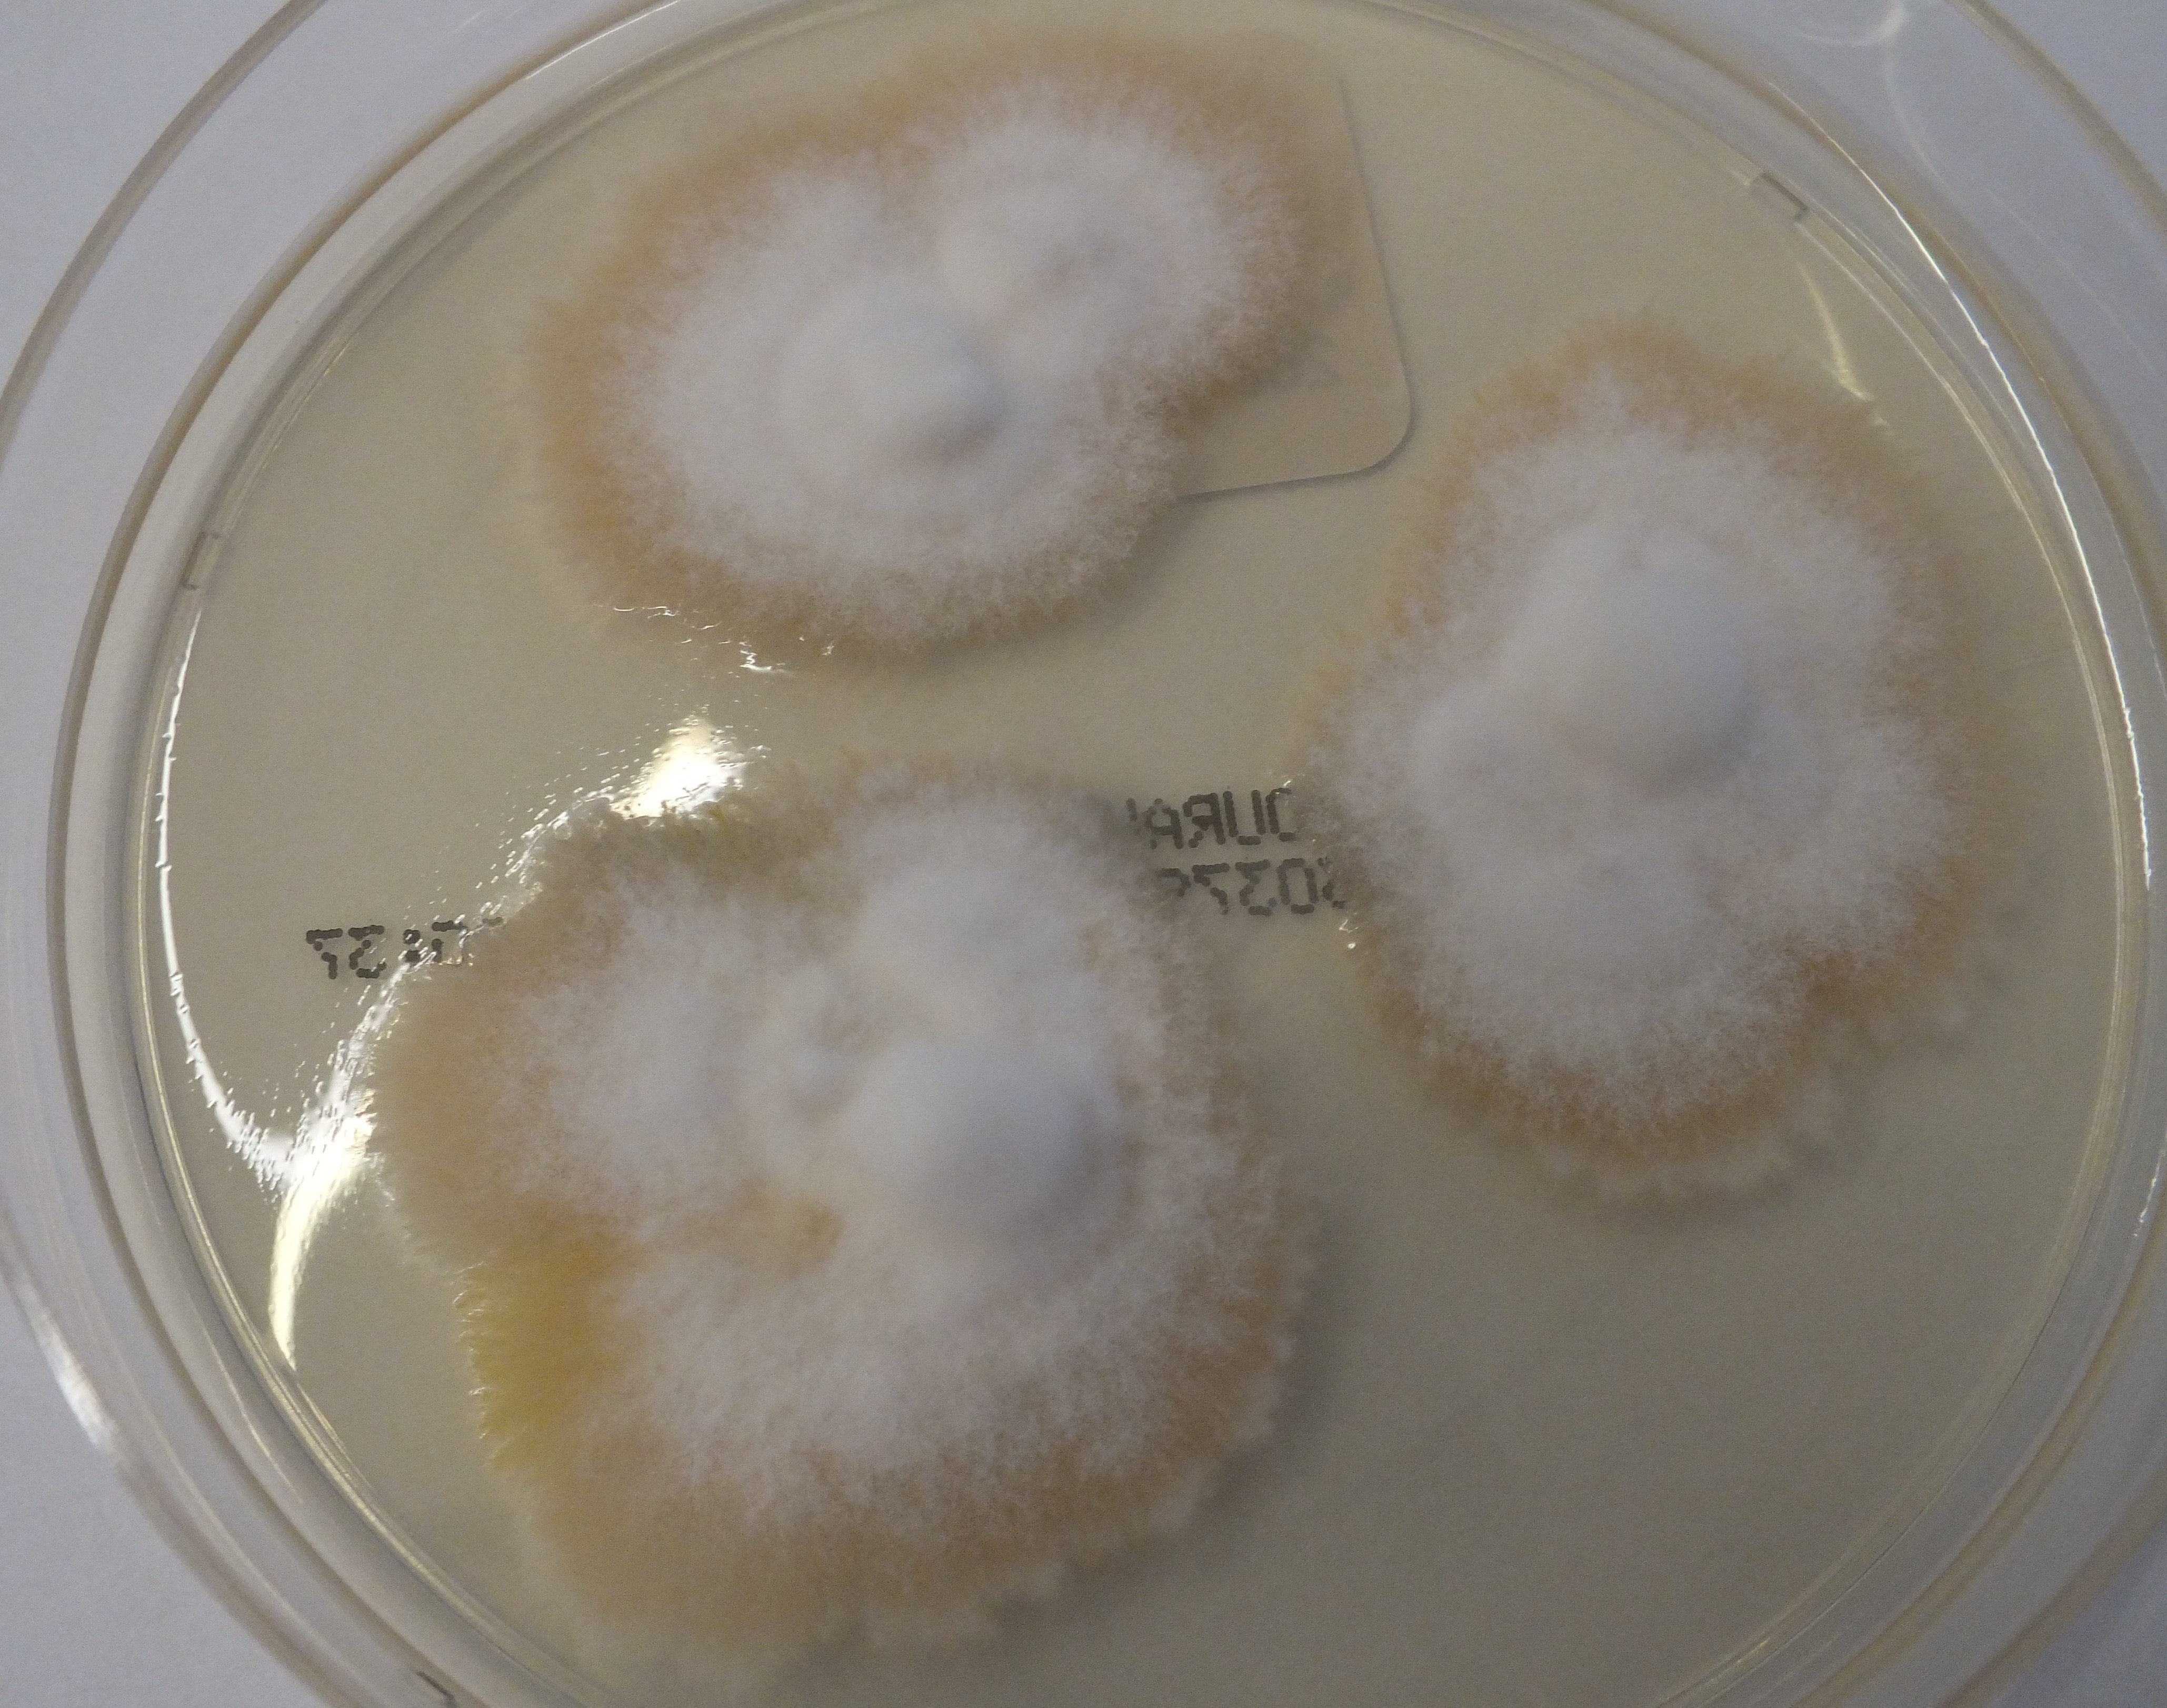
None
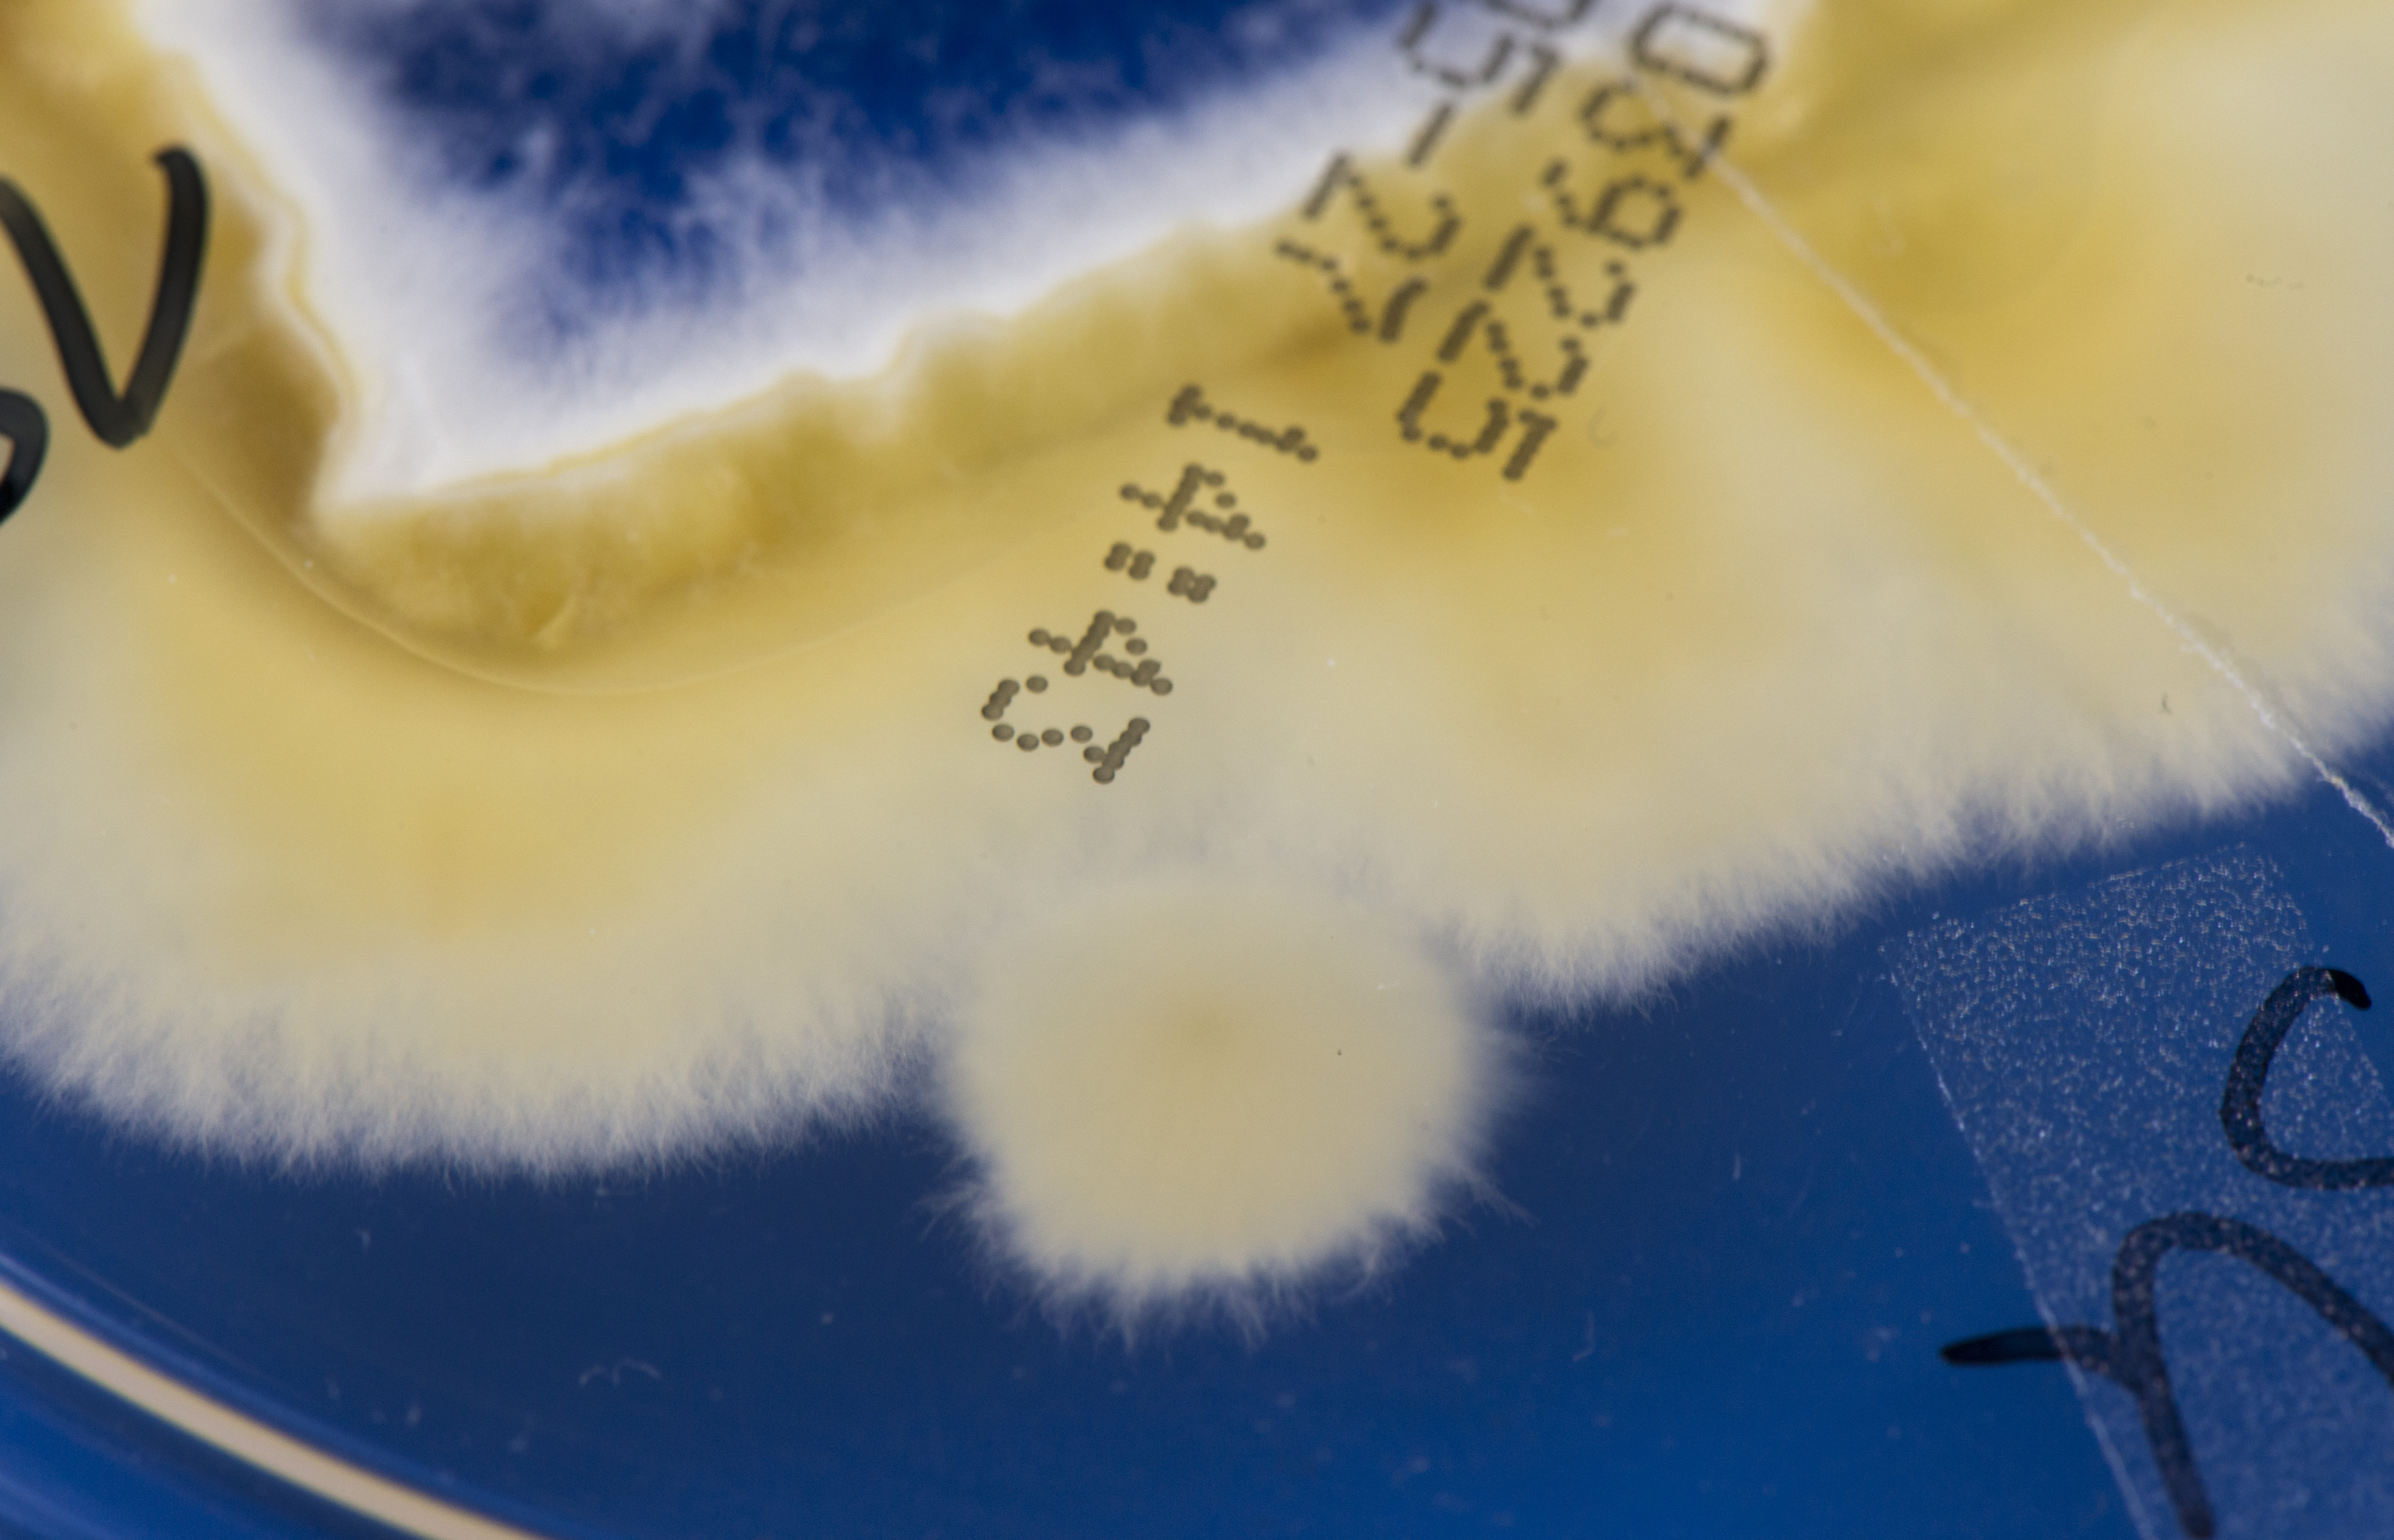
None

Arthroderma quadrifidum (früher Trichophyton terrestre) Durie et Frey 1957 & Dawson & Gentles 1961
Arthroderma (A.) quadrifidum ist ein ubiquitär im Erdboden vorkommender Dermatophyt, der früher unter dem Namen Trichophyton (T.) terrestre bekannt war. Dieser als apathogen angesehene Pilz wird gelegentlich aus klinischem Material – Nagelspänen oder Hautschuppen vom Fuß – angezüchtet. Der geophile Dermatophyt ist ein Saprophyt, der die Haut lediglich transitorisch kolonisiert. Ob A. quadrifidum im Einzelfall auch als pathogener Erreger einer Onychomykose in Erscheinung treten kann, ist umstritten und bislang nicht nachgewiesen.